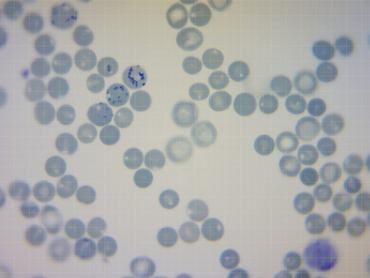

Több különböző országban lezajlott kutatás egybecsengő eredményei szerint a koronavírus-fertőzés szempontjából nem mindegy, hogy milyen a vércsoportunk. Ha ugyanis 0-ás, akkor kisebb eséllyel kapjuk el a vírust, és a betegség kimenetele is enyhébb lehet. Az A-s vércsoport viszont hátrány lehet a betegség szempontjából - kezdi bejegyzését a a Budai Egészségközpont infektológus szakorvosainak közreműködésével készült posztjában az Útikalauz Anatómiába egészségügyi szakblog.
A német, norvég és osztrák kutatások szerint az A-vércsoportúaknak 50 százalékkal nagyobb esélyük van arra, hogy súlyosabb lefolyású legyen esetükben a koronavírus-fertőzés, mint a többi vércsoportnak. A 0-ás vércsoportúak viszont a vizsgálatok szerint 50 százalékkal védettebbek a komolyabb megbetegedéssel szemben. A Grazi Orvosi Egyetem kutatása is hasonló eredményre jutott: szerint a 0-ás vércsoportú emberek egyértelműen ritkábban betegszenek meg, mint az A-, B-, vagy AB-vércsoporttal rendelkezők. Viszont az osztrák orvosok a lefolyás súlyosságát nézve nem láttak olyan összefüggést, hogy a nullás vércsoportú betegek könnyebben gyógyulnak.
Az Rh-negatív vércsoport szintén előny lehet: egy kanadai kutatás során 225 ezer embert teszteltek, és megállapították, hogy ebbe a vércsoportba tartozók esetében 12 százalékkal kevesebbszer született pozitív COVID-19 diagnózis, mint a többieknél. A pozitív esetekben pedig a súlyos megbetegedés, illetve a halálozás kockázata 13 százalékkal volt kisebb náluk, mint a többi esetében.
A jelenségre egyelőre nem találták meg a magyarázatot.
Egy másik friss kutatás szerint a súlyos állapotból felépült fertőzöttek újra kórházba kerülhetnek a betegség miatt.